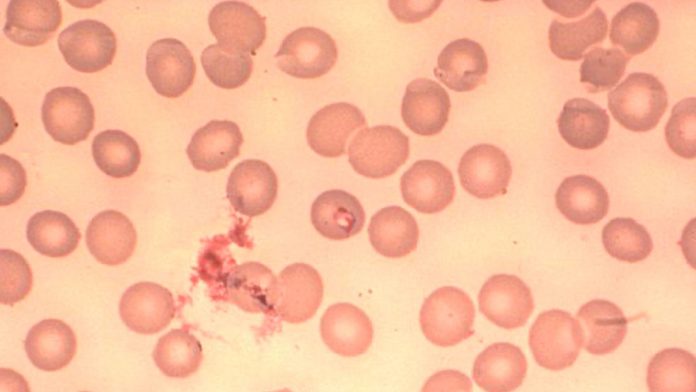

Los Centros para el Control y la Prevención de Enfermedades de EE.UU. (CDC, por sus siglas en inglés) reportaron este viernes, en un informe semanal, que los casos de babesiosis, una enfermedad transmitida por las garrapatas, aumentaron un 25 % entre 2011 y 2019 en algunas localidades del noreste y medio oeste del país.
Esta afección es ocasionada por el parásito ‘Babesia microti’, que infecta a los glóbulos rojos de la sangre de los humanos picados por una garrapata de patas negras (‘Ixodes scapularis’), también conocida como la ‘garrapata del venado’.
A pesar de que ciertas personas con babesiosis son asintomáticas, otras desarrollan síntomas semejantes a los de la gripe, como fiebre, dolores corporales, escalofríos, náuseas y fatiga. No obstante, esta enfermedad puede ser grave y hasta fatal en personas que tengan sistemas inmunitarios debilitados u otros factores de riesgo.
Los CDC documentaron que más del 98 % de los casos de babesiosis habían sido notificados en los estados de Connecticut, Wisconsin, Massachusetts, Minnesota, Nueva Jersey, Nueva York, Rhode Island, Vermont, Nuevo Hampshire y Maine.
La agencia de salud pública consideró la afección como endémica en los primeros siete estados antes de 2011, pero no en los últimos tres. Esto se debe a que la tasa de infecciones en Vermont se elevó de 2 casos en 2011 a 34 en 2019, en Nuevo Hampshire de 13 a 63 y en Maine de 9 a 138.
El cambio climático aumenta la población de garrapatas
Los expertos argumentaron que uno de los factores que podría estar causando un incremento en los casos es el aumento de las temperaturas a nivel mundial, que provoca veranos más largos e inviernos más cortos. Esto propicia que el número de garrapatas se eleve, ya que estos ácaros crecen en climas cálidos y húmedos. Otro factor es la creciente población de ciervos.
De acuerdo con el doctor Peter Krause, científico de la Escuela de Salud Pública de Yale, el informe de los CDC resalta «un hito desafortunado en el surgimiento de la babesiosis en Estados Unidos», por lo que «más casos significan más enfermedades» que conducen a la muerte de algunos.
«Las personas que pasan tiempo al aire libre en estados con babesiosis endémica deben prevenir las picaduras de garrapatas, lo que incluye usar pantalones largos, evitar la maleza y el pasto alto y usar repelentes para garrapatas», concluye el informe de los CDC.





